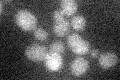
YPL268W
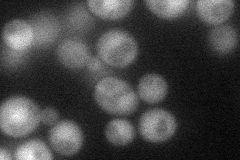
YPL268W
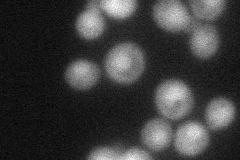
YPL268W
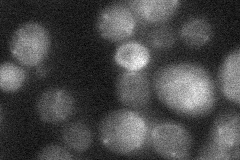
YPL268W
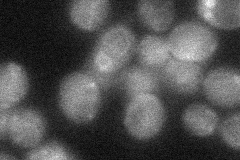
YPL268W

View description
Phospholipase C, hydrolyzes phosphatidylinositol 4,5-biphosphate (PIP2) to generate the signaling molecules inositol 1,4,5-triphosphate (IP3) and 1,2-diacylglycerol (DAG); involved in regulating many cellular processes
Localization:
Intensity:
Fold change:
Significance:
-
C’ GFP library in SD
below threshold14.25 -
N' NOP1pr-GFP in SD
cytosol,nucleus46.0414 -
N' TEF2pr-mCherry in SD
nucleus30.423 -
N' NATIVEpr-GFP in SD
below threshold19.345 -
N' TEF2pr-VC and Cyto-VN in SD
cytosol30.7296 -
C’ GFP library in SD+DTT

cytosol16.21.13No -
C’ GFP library in SD+H2O2

cytosol15.21.06No -
C’ GFP library in Starvation Media

cytosol16.691.17No -
C’ GFP library on the background of Pup2-DaMP

N/A -
C’ GFP library on the background of CCT mutant

N/A0N/AYes
